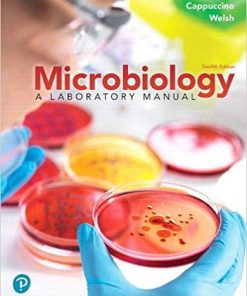
Microbiology A Laboratory Manual 12th Ed

Sale!
Cardiology Books
ISBN 9783030457914
Original price was: ₨ 3,500.₨ 3,000Current price is: ₨ 3,000.
Sale!
Audiology Books
ISBN 9783805581004
Original price was: ₨ 700.₨ 550Current price is: ₨ 550.
Sale!
Endocrinology Books
Microbial Endocrinology Interkingdom Signaling in Infectious Disease and Health 2nd Edition
ISBN 9783319202143
Original price was: ₨ 2,000.₨ 1,700Current price is: ₨ 1,700.
Sale!
Microbiology Books
ISBN 9780135188996
Original price was: ₨ 3,000.₨ 2,400Current price is: ₨ 2,400.
Sale!
Cardiology Books
ISBN 9783030478001
Original price was: ₨ 1,500.₨ 1,100Current price is: ₨ 1,100.
Sale!
Cardiology Books
ISBN 9783319545783
Original price was: ₨ 2,000.₨ 1,700Current price is: ₨ 1,700.
Sale!
Cardiology Books
ISBN 9781608053322
Original price was: ₨ 1,000.₨ 700Current price is: ₨ 700.